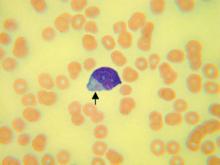
AUER小體

簡介
Auer小體是急性非淋巴細胞白血病一個具有診斷意義的形態學特徵,其在急非淋的檢出、分布情況及與療效的關係有診斷性的臨床意義。
原文
 AUER體顯微鏡下圖
AUER體顯微鏡下圖 AUER小體
AUER小體In acute myeloid leukemia, blast cellsare generally larger, with more plentiful cytoplasm that may contain granules orAuer rods
參考 西氏內科學 第24版

Auer小體:在瑞氏或吉姆薩 的血或骨髓塗片中,白細胞胞質中出現染紅色細桿狀物質,1條或數條不等,長1~6um,稱為Auer小體(棒狀小體),這種Auer小體可出現在急粒、急單和急粒-單白血病細胞漿內,但不見於急淋白血病,在骨髓增生異常綜合徵(MDS)的RAEB-t型也可檢出。
Auer小體是急性非淋巴細胞白血病一個具有診斷意義的形態學特徵,其在急非淋的檢出、分布情況及與療效的關係有診斷性的臨床意義。
 AUER體顯微鏡下圖
AUER體顯微鏡下圖 AUER小體
AUER小體In acute myeloid leukemia, blast cellsare generally larger, with more plentiful cytoplasm that may contain granules orAuer rods
參考 西氏內科學 第24版
名詞定義 髓樣小體在某些細胞中尚可見到由單位膜包圍,內有成堆的成螺紋或網狀排列的嗜鋨性的膜性成份小體,它對酸性磷酸酶呈陽性,稱為髓樣小體(myelinbody)。 相關小體 auer小體 核小體髓樣小體 ...
名詞定義 相關小體減低。骨髓中原始粒細胞大於90%(NEC),白血病細胞內可見Auer小體...%,白血病細胞內可見Auer小體,幼紅細胞及巨核細胞明顯減少,此型白血病細胞...%,Auer小體易見。血小板中度到重度減少。2.骨髓象: 多數病例骨髓增生極度...
一類總稱 合格列表 反洗錢 開發環境 親和性的白血病細胞內可見Auer小體。分兩個亞型:M2a:骨髓中原粒I型+II型...Auer小體,也可逸出胞體之外。5、急性粒-單細胞型白血病(M4) :骨髓...Auer小體,巨核細胞顯著減少。8、急性巨核細胞白血病(M7型) :骨髓增生...
概述 免疫學分型 症狀 病因 急性白血病的檢查方式,無顆粒,無Auer小體。(2) M1(急性原始粒細胞白血病未分化型)骨髓...10%,約50%病例的白血病細胞內可見Auer小體。分兩個亞型:M2a...漿可見束狀Auer小體,也可逸出胞體之外。(5) M4(急性粒-單核細胞...
MICM分型 FAB分型 免疫學分型 細胞遺傳學分型 MICM分型的意義)早幼粒細胞少見中幼粒細胞以下階段不見或罕見;可見Auer小體紅系...Auer小體;紅系巨核細胞系增生受抑根據粒細胞分化程度不同又分為:Ma型:原...可見細小Auer小體;紅系粒系及巨核細胞系增生受抑根據單核細胞分化...
病因 白血病分類 症狀 檢查 治療%~40%為t(8;21),且Auer小體常陽性。免疫表型除具髓系特點外,可...概述 急性粒細胞白血病部分分化型(M2),粒系明顯增生,可見AUER小體;紅系、巨核細胞系增生受抑。根據粒細胞分化程度不同又分為分兩個亞型...
,粒細胞系統可有核漿發育不平衡現象,胞漿內有時可見Auer小體;紅細胞系統幼...單垓細胞,原始單核細胞內可見Auer小體。巨核細胞系統病變:巨核細胞增多...瘧原蟲,黑熱病原蟲利杜小體等。相關疾病骨髓形態學診斷一定要結合臨床查體,如肝...
骨髓細胞參考值 臨床意義 相關疾病-Huët 畸形。部分胞漿內出現Auer小體。巨核細胞在數和質方面均可有異常...體積大或呈卵園形,有嗜鹼點彩、核碎裂和Howell-Jolly小體。RA...
病症簡介 疾病原因 症狀表現 實驗室檢查 診斷